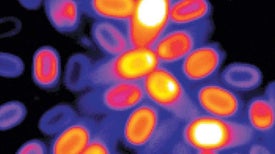

Scientists Create Cyborg Bacteria
Bacteria with artificial hydrogel skeletons could be used as tiny robots

Bacteria with artificial hydrogel skeletons could be used as tiny robots

Just two genes get tiny synthetic cells moving, offering clues to life’s evolution

A microbial discovery could help guide the search for life beyond Earth

These two researchers journey toward the center of Earth—via windows to the crust—to find bacteria that can breathe iron, arsenic and other metals that would kill us pretty quickly...

Wherever we dig and however deep we dig, we find microscopic living organisms. Could they eat the carbon we’re pumping into the air?

Scientists are on a mission to save parasites—not to kill them. Climate change is already doing an increasingly good job at the latter, and that could be a big problem for the world...

The pandemic fungus in the television program The Last of Us is real. But an expert says other fungi are much more threatening to humans

Urinary tract infections are increasingly becoming resistant to first-line antibiotics, and this may be a warning for our ability to treat other microbial infections

Mycologist Flora Patterson helped make the USDA fungus collection into the world’s largest. She also made a mean mushroom “catsup”
Do sleeping spores dream of electric sheep?

Clusters of bacteria and fungi seem to be capable of complex movement, setting tooth decay in motion

A new chip re-creates the human vagina’s unique microbiome

The parasite Toxoplasma gondii can change the behavior of infected wolves in ways that make them more likely to be pack leaders

A virologist explains what it takes for a virus to leap from an animal host into humans

Prevent your jack-o’-lantern from turning into moldy, maggoty mush before Halloween

In case you missed it

Bacterial predators fight like wolves, torpedoes and vampires, and they could provide the next antibiotics

Researchers design an artificial neuron that can trigger closure of a Venus flytrap.

These organisms’ private “mucospheres” play an outsize role in the planet’s carbon cycle

A key player is revealed in the acne-causing immune battle
Support science journalism.

Thanks for reading Scientific American. Knowledge awaits.
Already a subscriber? Sign in.
Thanks for reading Scientific American. Create your free account or Sign in to continue.
Create Account